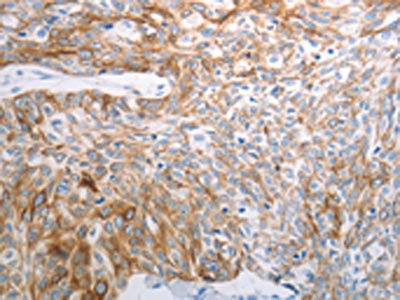

PAK1 Antibody
-
中文名稱:PAK1兔多克隆抗體
-
貨號:CSB-PA116147
-
規格:¥1100
-
圖片:
-
The image on the left is immunohistochemistry of paraffin-embedded Human esophagus cancer tissue using CSB-PA116147(PAK1 Antibody) at dilution 1/25, on the right is treated with synthetic peptide. (Original magnification: ×200)
-
Gel: 10%SDS-PAGE, Lysate: 40 μg, Lane: 293T cells, Primary antibody: CSB-PA116147(PAK1 Antibody) at dilution 1/450, Secondary antibody: Goat anti rabbit IgG at 1/8000 dilution, Exposure time: 1 minute
-
-
其他:
產品詳情
-
Uniprot No.:
-
基因名:
-
別名:ADRB2 antibody; Alpha PAK antibody; Alpha-PAK antibody; MGC130000 antibody; MGC130001 antibody; p21 activated kinase 1 antibody; p21 protein (Cdc42/Rac) activated kinase 1 antibody; p21-activated kinase 1 antibody; p21/Cdc42/Rac1 activated kinase 1 (yeast Ste20 related) antibody; p21/Cdc42/Rac1-activated kinase 1 (STE20 homolog, yeast) antibody; p65 PAK antibody; p65-PAK antibody; P68-PAK antibody; PAK alpha antibody; PAK-1 antibody; Pak1 antibody; PAK1_HUMAN antibody; Paka antibody; PAKalpha antibody; Protein kinase MUK2 antibody; Rac/p21-activated kinase antibody; Serine/threonine-protein kinase PAK 1 antibody; STE20 homolog yeast antibody
-
宿主:Rabbit
-
反應種屬:Human,Mouse,Rat
-
免疫原:Synthetic peptide of Human PAK1
-
免疫原種屬:Homo sapiens (Human)
-
標記方式:Non-conjugated
-
抗體亞型:IgG
-
純化方式:Antigen affinity purification
-
濃度:It differs from different batches. Please contact us to confirm it.
-
保存緩沖液:-20°C, pH7.4 PBS, 0.05% NaN3, 40% Glycerol
-
產品提供形式:Liquid
-
應用范圍:ELISA,WB,IHC
-
推薦稀釋比:
Application Recommended Dilution ELISA 1:1000-1:5000 WB 1:200-1:1000 IHC 1:25-1:100 -
Protocols:
-
儲存條件:Upon receipt, store at -20°C or -80°C. Avoid repeated freeze.
-
貨期:Basically, we can dispatch the products out in 1-3 working days after receiving your orders. Delivery time maybe differs from different purchasing way or location, please kindly consult your local distributors for specific delivery time.
-
用途:For Research Use Only. Not for use in diagnostic or therapeutic procedures.
相關產品
靶點詳情
-
功能:Protein kinase involved in intracellular signaling pathways downstream of integrins and receptor-type kinases that plays an important role in cytoskeleton dynamics, in cell adhesion, migration, proliferation, apoptosis, mitosis, and in vesicle-mediated transport processes. Can directly phosphorylate BAD and protects cells against apoptosis. Activated by interaction with CDC42 and RAC1. Functions as GTPase effector that links the Rho-related GTPases CDC42 and RAC1 to the JNK MAP kinase pathway. Phosphorylates and activates MAP2K1, and thereby mediates activation of downstream MAP kinases. Involved in the reorganization of the actin cytoskeleton, actin stress fibers and of focal adhesion complexes. Phosphorylates the tubulin chaperone TBCB and thereby plays a role in the regulation of microtubule biogenesis and organization of the tubulin cytoskeleton. Plays a role in the regulation of insulin secretion in response to elevated glucose levels. Part of a ternary complex that contains PAK1, DVL1 and MUSK that is important for MUSK-dependent regulation of AChR clustering during the formation of the neuromuscular junction (NMJ). Activity is inhibited in cells undergoing apoptosis, potentially due to binding of CDC2L1 and CDC2L2. Phosphorylates MYL9/MLC2. Phosphorylates RAF1 at 'Ser-338' and 'Ser-339' resulting in: activation of RAF1, stimulation of RAF1 translocation to mitochondria, phosphorylation of BAD by RAF1, and RAF1 binding to BCL2. Phosphorylates SNAI1 at 'Ser-246' promoting its transcriptional repressor activity by increasing its accumulation in the nucleus. In podocytes, promotes NR3C2 nuclear localization. Required for atypical chemokine receptor ACKR2-induced phosphorylation of LIMK1 and cofilin (CFL1) and for the up-regulation of ACKR2 from endosomal compartment to cell membrane, increasing its efficiency in chemokine uptake and degradation. In synapses, seems to mediate the regulation of F-actin cluster formation performed by SHANK3, maybe through CFL1 phosphorylation and inactivation. Plays a role in RUFY3-mediated facilitating gastric cancer cells migration and invasion. In response to DNA damage, phosphorylates MORC2 which activates its ATPase activity and facilitates chromatin remodeling. In neurons, plays a crucial role in regulating GABA(A) receptor synaptic stability and hence GABAergic inhibitory synaptic transmission through its role in F-actin stabilization. In hippocampal neurons, necessary for the formation of dendritic spines and excitatory synapses; this function is dependent on kinase activity and may be exerted by the regulation of actomyosin contractility through the phosphorylation of myosin II regulatory light chain (MLC). Along with GIT1, positively regulates microtubule nucleation during interphase.
-
基因功能參考文獻:
- PAK1 gene silencing decreases proliferation of MHCC97-H cells, HepG2 cells and cells in xenograft tumor through the p53/p21 pathway. PMID: 29802374
- PAK1 silencing attenuated cell cycle progression, inducing apoptosis. Inhibition of PAK1 expression reduced tumor sizes and masses by modulating CREB expression and activation. PMID: 30282071
- Once activated, c-Abl kinase regulated the activity of Vav1, which further affected Rac1/PAK1/LIMK1/cofilin signaling pathway. PMID: 29058761
- The nuclear functions of PAK1 and its role in the regulation of DNA damage repair is reviewed. PMID: 29597073
- PAK1 is upregulated in cutaneous T cell lymphoma. PAK1 silencing induced apoptosis and inhibited cell growth by stimulating the expression of PUMA and p21. PMID: 29307600
- Results show that JMJD6 regulates the alternative splicing of PAK1 in melanoma cells. PMID: 29187213
- PAK1 expression, evaluated by immunohistochemistry, was positively correlated with pERK and beta-catenin expression in lung tumors. Patients with high-PAK1, high-pERK, and high-nuclear beta-catenin tumors more frequently showed an unfavorable response to cisplatin-based chemotherapy when compared to their counterparts. PMID: 27713506
- PKC-zeta may be responsible for the abnormal growth, proliferation, and migration of metastatic LOVO colon cancer cells via PKC-zeta/Rac1/Pak1/beta-Catenin pathway. PMID: 29408512
- High expression of PAK1 is associated with invasion of gastric cancer. PMID: 28534988
- Molecular modelling studies of PAK1 with its major interacting partners RHOA and STAT3 revealed potential network gene elements in breast invasive carcinoma. PMID: 27456030
- miR4855p reverses EMT and promotes cisplatin-induced cell death by targeting PAK1 in oral tongue squamous cell carcinoma. This study suggests that PAK1 plays an essential role in the progression of OSCC and it is a potential therapeutic target for OSCC. PMID: 28535002
- Because reduced PAK1 activity impaired FA/BRCA function, inhibition of this kinase in PAK1 amplified and/or overexpressing breast cancer cells represents a plausible strategy for expanding the utility of PARP inhibitors to FA/BRCA-proficient cancers. PMID: 27740936
- Overall, the authors find that p27 directly promotes cell invasion by facilitating invadopodia turnover via the Rac1/PAK1/Cortactin pathway. PMID: 28287395
- Results show that Pak1 is overexpressed in breast cancer cells and tissues, and found that Pak1 is a hormone responsive gene, whose expression can be modulated by steroid hormones, estrogen (E2) and progesterone (P4). Pak1 promoter analysis showed that PR mediates promoter activity via its binding to PRE present on the Pak1 promoter. PMID: 29274909
- PAK1 confers TKI resistance in EGFR-mutant cells as well as in EGFR-wild-type cells. PMID: 27178741
- Our findings offer an insight for the new drug development of PAK1 inhibitor. We also provide a possible explanation for the phenomenon that the application of the chlorhexidine in peritoneal lavage inhibited the development of tumor. PMID: 29146188
- To our knowledge, this is the first study illustrating the mechanistic role of Pak1 in causing gemcitabine resistance via multiple signaling crosstalks, and hence Pak1-specific inhibitors will prove to be a better adjuvant with existing chemotherapy modality for pancreatic ductal adenocarcinoma (PDAC) PMID: 27117533
- Studies indicate that PAK1 expression may be a predictive marker of overall survival and disease-specific survival in patients with solid tumors. PMID: 27027431
- Results from our analysis showed that Pak1 overexpression, knockdown and Pak1 knockout cell line models showed that Pak1 confers protection to keratinocytes from UV-B-induced apoptosis and DNA damage via ATR. PMID: 28692051
- the oxidative stress-induced down-regulation of PAK1 activity could be involved in the loss of mesencephalic dopaminergic neurons. PMID: 27121078
- the expression of PAK1 is inversely correlated with the level of miR-494 in human breast cancer samples. Furthermore, re-expression of PAK1 partially reverses miR-494-mediated proliferative and clonogenic inhibition as well as migration and invasion suppression in breast cancer cells PMID: 28055013
- Our study revealed that PAK1 may play a crucial role in the progression of OSCC. Studying the role of PAK1 and its substrates is likely to enhance our understanding of oral carcinogenesis and potential therapeutic value of PAKs in oral cancer. PMID: 27229476
- The effect of PAK1 modulation on tumorigenesis, and on resistance to treatment with 5-fluorouracil (5-FU), was measured by sphere formation in vitro and by growth of xenografted tumors in vivo. The results show that PAK1 activity correlated with the expression of CSC markers and the CD44 isoform profile, and with tumor growth both in vitro and in vivo. PMID: 27260988
- this study shows that PAK1 may be a potential tumor marker and therapeutic target of prostate cancer PMID: 28186966
- Our results from clinical samples also suggest that Threonine 209 phosphorylation by Pak1 could be a potential therapeutic target and of great clinical relevance with implications for Runx3 inactivation in cancer cells where Runx3 is known to be oncogenic. The findings presented in this study provide evidence of Runx3-Threonine 209 phosphorylation as a molecular switch in dictating the tissue-specific dualistic functions PMID: 26898755
- Abnormalities in the PAK1 and PAK3 mRNA levels as well as their altered coexpression patterns were observed in the postmortem brain of subjects with depression. Dysregulated PAK1/PAK3 dependent signaling may be a key factor responsible for volumetric abnormalities observed in the hippocampus and in the prefrontal cortex in depression resulting in altered connectivity of these regions. PMID: 27474226
- Short-term treatment of nascent melanoma tumors with PAK inhibitors that block RhoJ signaling halts the growth of BRAF mutant melanoma tumors in vivo and induces apoptosis in melanoma cells in vitro via a BAD-dependent mechanism PMID: 28753606
- these data strongly support a critical interplay between prolactin and estrogen via PAK1 and suggest that ligand-independent activation of ERalpha through prolactin/PAK1 may impart resistance to anti-estrogen therapies. PMID: 26944939
- Given the central role of p21-Activated kinase 1 (PAK1) in vital signaling pathways, studies suggest that clinical development of PAK1 inhibitors will require careful investigation of their safety and efficacy. PMID: 28202661
- These findings suggest that small-molecule inhibitors of Pak1 may have a therapeutic role in the ~25% of ovarian cancers characterized by PAK1 gene amplification. PMID: 26257058
- autocrine VEGF and IL-8 promoted endothelial cell migration via the Src/Vav2/Rac1/PAK1 signaling pathway. PMID: 28278510
- These data provide insight into the mechanisms guiding PRL-mediated breast cancer cell motility and invasion and highlight a significant role for phosphoTyr-PAK1 in breast cancer metastasis. PMID: 27542844
- p120 participates in the progress of gastric cancer through regulating Rac1 and Pak1. PMID: 26324182
- The role of PAK1 in cancer drug resistance in BRAF-mutated cancer PMID: 28052407
- High p21-activated kinase 1 and cell division control protein 42 homolog expressions are closely related to the clinicopathological features and poor prognosis of cervical carcinoma, serving as unfavorable prognostic factors. PMID: 27060895
- miR7 negatively regulates PAK1 protein expression but has no effect on PAK1 mRNA expression. Knockdown of PAK1 expression markedly suppressed thyroid cancer cell proliferation, migration and invasion. PMID: 27430434
- Myricetin effectively suppressed the protein expression of p21-activated kinase 1 (PAK1). PMID: 27122002
- overexpression of PAK1, NEK6, AURKA, and AURKB genes in patients with Colorectal adenomatous polyp and colorectal cancer in the Turkish population. PMID: 26423403
- Pak1 expression is not associated with breast cancer recurrence and resistance to tamoxifen. PMID: 27056567
- 1alpha,25-Dihydroxy-Vitamin D3 leads to disruption of RAC1 and PAK1 activity with subsequent actin depolymerization of endometrial carcinoma cells. PMID: 27997893
- Study acts as a further supplement of the genetic features of neuroendocrine tumors. Somatic mutations of three potential tumor-related genes (HRAS, PAK1 and MEN1) might contribute to the tumorigenesis of thymic neuroendocrine tumors with EAS. PMID: 27913610
- PAK1-cofilin phosphorylation mechanism to mediate lung adenocarcinoma cells migration promoted by apelin-13 PMID: 26918678
- PAK-1 overexpression may be involved in colorectal carcinoma progression and could be considered an independent predictor of disease recurrence. PMID: 26884861
- Combination of a PAK1 inhibitor such as FRAX597 with cytotoxic chemotherapy deserves further study as a novel therapeutic approach to pancreatic cancer treatment. PMID: 26774265
- beta-elemene enhances radiosensitivity of gastric cancer cells by inhibiting Pak1 signaling. PMID: 26379399
- PAK1 nuclear translocation is ligand-dependent: only PRL but not E2 stimulated PAK1 nuclear translocation PMID: 27003261
- These findings indicate that genetic variants in PAK1 gene may contribute to susceptibility to lung cancer in the Chinese population. PMID: 26377044
- Formation of filopodia by membrane glycoprotein M6a (Gpm6a) requires actin regulator coronin-1a (Coro1a), known to regulate plasma membrane localization and activation of Rac1 and its downstream effector Pak1. PMID: 26809475
- This study showed that PAK1 messenger RNA levels were significantly downregulated specifically in deep layer 3 pyramidal cells in patient with schizophrenia. PMID: 25981171
- Data show association of G protein-coupled receptor kinase-interacting protein 1 (GIT1), p21-activated kinase interacting exchange factor (betaPIX), and p21 protein (Cdc42/Rac)-activated kinase 1 (PAK1) with centrosomes. PMID: 27012601
顯示更多
收起更多
-
亞細胞定位:Cytoplasm. Cell junction, focal adhesion. Cell projection, lamellipodium. Cell membrane. Cell projection, ruffle membrane. Cell projection, invadopodium. Nucleus, nucleoplasm. Chromosome. Cytoplasm, cytoskeleton, microtubule organizing center, centrosome.
-
蛋白家族:Protein kinase superfamily, STE Ser/Thr protein kinase family, STE20 subfamily
-
組織特異性:Overexpressed in gastric cancer cells and tissues (at protein level).
-
數據庫鏈接:
Most popular with customers
-
YWHAB Recombinant Monoclonal Antibody
Applications: ELISA, WB, IHC, IF, FC
Species Reactivity: Human, Mouse, Rat
-
Phospho-YAP1 (S127) Recombinant Monoclonal Antibody
Applications: ELISA, WB, IHC
Species Reactivity: Human
-
-
-
-
-
-